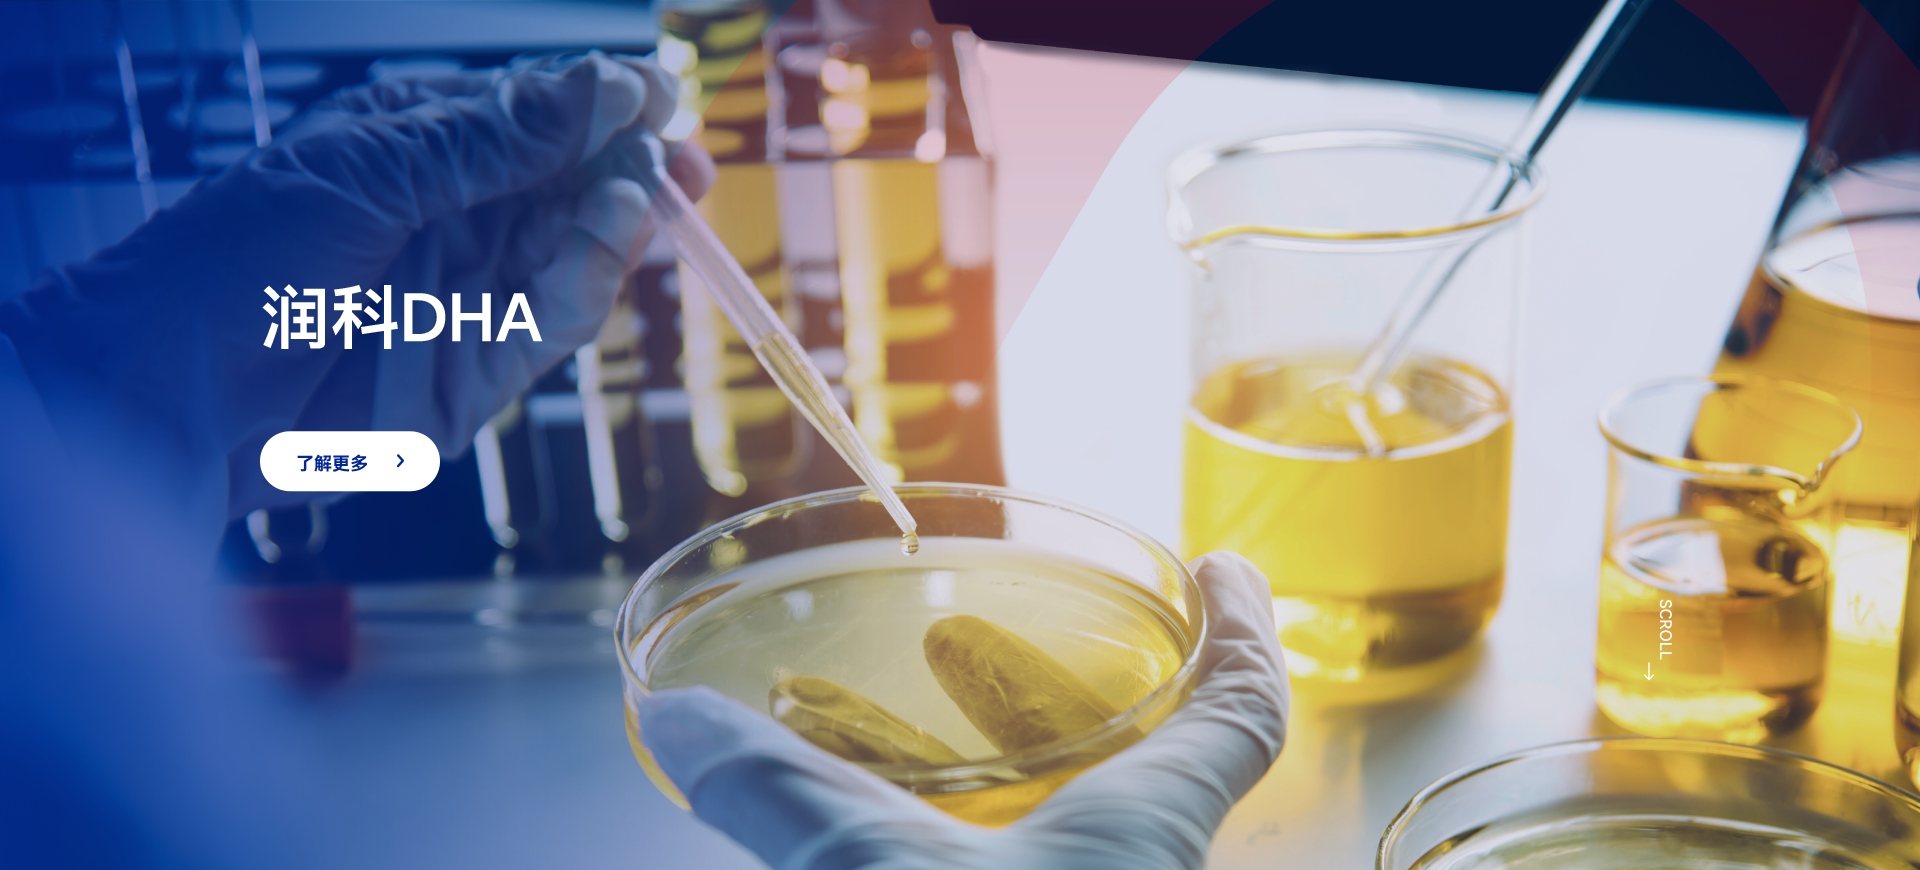

应用场景

功能性休闲食品

膳食营养补充剂


婴幼儿配方食品

水产畜牧补充剂

宠物营养补充剂

特殊医学用途配方食品


关于 润科
润科生物成立于2000年,是国内第一家应用现代生物工程技术进行研发、生产高品质营养原料及健康产品的企业。全资子公司福建润科2012年7月被认定为国家“高新技术企业”,全资子公司广东沛智2025年12月被认定为国家“高新技术企业”。
目前,润科生物已荣膺一百多项国家级和省级荣誉, 参与DHA、ARA等7项国家、行业标准的起草、制定,两度入选《福布斯中国潜力100强企业榜》。
25000
100
7
超
㎡
超
项
项
自建生产基地
国家、省级荣誉
国家、行业标准参与起草企业


主营业务

功能营养素原料
DHA/ARA/元宝枫籽油

定制营养食品
复配营养强化剂
软胶囊/凝胶糖果


我们即刻回应
为您提供精准高效的联系与服务